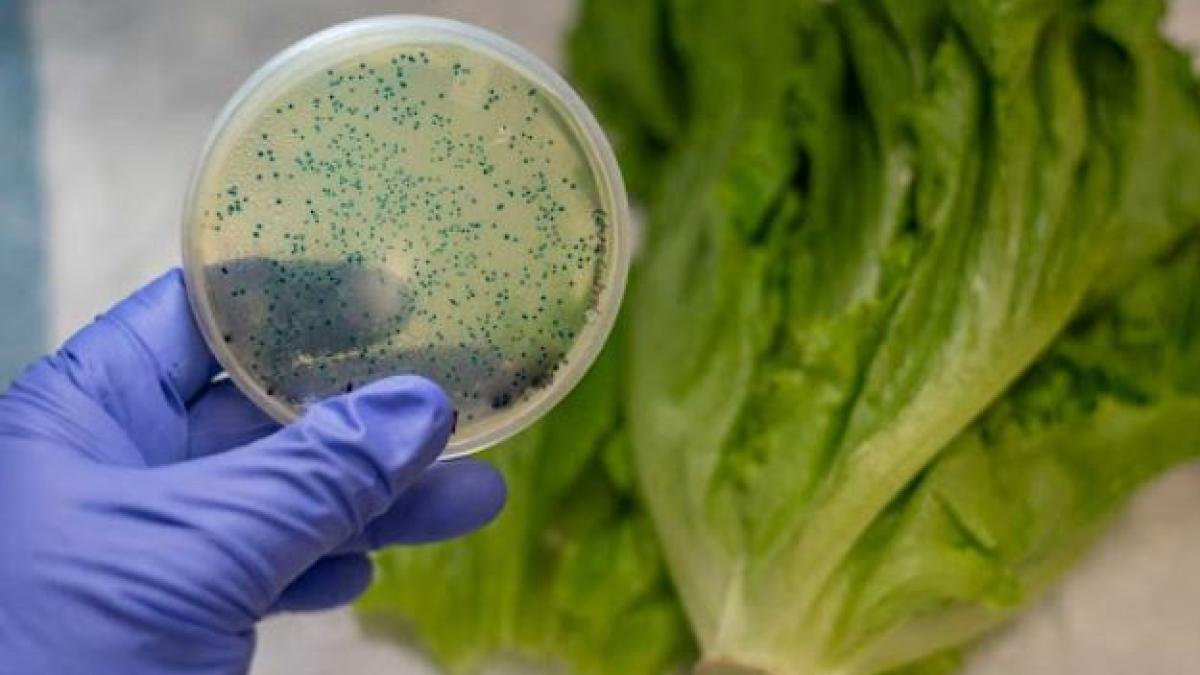
epidemie-de-norovirus-la-rasnov--peste-140-de-persoane-s-au-prezentat-la-medic

"În ancheta epidemiologică au fost raportate 140 de persoane care au fost înregistrate de către unităţile sanitare, evoluţia acestor pacienţi fiind favorabilă. (...) Din cei 140 pacienţi cu simptomatologie digestivă, 25 s-au prezentat la unităţi spitaliceşti, iar un caz - un copil de 5 ani, la care s-a identificat din materii fecale Norovirus G2 - a fost spitalizat, având o evoluţie clinică bună. De asemenea, în cazul unui alt copil s-au recoltat probe biologice (materii fecale), rezultând infectarea acestuia cu Norovirus, care este recunoscut ca fiind responsabil pentru epidemii de acest tip. Din acest moment, considerăm aceasta ca fiind cauza cea mai probabilă a focarului de boală transmisibilă apărut în oraşul Râşnov", a precizat DSP Braşov într-un comunicat de presă.
Totodată, autoritatea sanitară braşoveană a prelevat probe din reţeaua de apă a oraşului Râşnov, care, la evaluarea de etapă, nu arată contaminarea cu germeni patogeni. Ancheta epidemiologică este în desfăşurare, a menţionat sursa citată. DSP Braşov menţionează că infecţia cu Norovirus sau virusul Norwalk este denumită popular "gripa stomacului", deşi nu are nimic în comun cu infecţia gripală.
Afecţiune contagioasă, care se transmite extrem de rapid
Infecţia cu Norovirus este o afecţiune contagioasă care se transmite extrem de rapid. Expunerea la numai 18 particule de virus poate conduce la infectare, prin comparaţie cu cele aproape 1.000 de particule, în cazul gripei. Modalitatea de transmitere a acestui virus este multiplă: prin contactul cu persoane bolnave, prin contactul cu suprafeţe contaminate, prin consumul de alimente şi/sau băuturi contaminate.
Alimentele pot răspândi virusul dacă au fost manipulate de către persoane bolnave, mai ales dacă nu se păstrează o igiena corespunzătoare a mâinilor, sau dacă au fost contaminate la sursă (în cazul peştelui, fructelor, legumelor). Pericolul de infectare cu Norovirus este maxim în cazul felurilor de mâncare ce nu au fost preparate termic. De asemenea, instrumentele folosite în bucătărie pot fi infectate şi astfel devin răspunzătoare pentru răspândirea rapidă a acestui virus.
[citeste si]